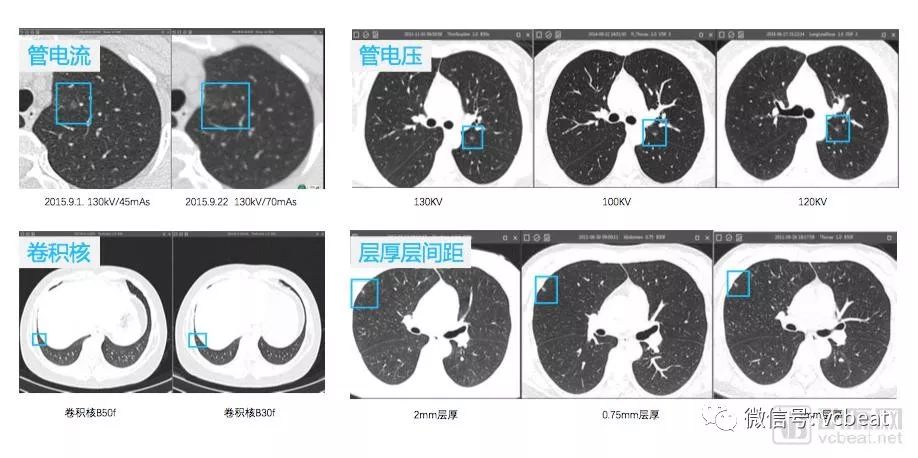

医疗AI场景应用与盈利模式探讨,医院愿意为怎样的AI项目付费?
新一代的人工智能能否掀起工业革命?这不仅仅是AI开发企业的问题,也是医生、患者等AI技术受益方关心的问题。
4月12日下午,同渡资本主办,动脉网、清华经管学院协办的同渡时光第12次沙龙“‘医疗+AI’路在何方”对新一代人工智能在医疗领域的应用价值及商业化潜力进入了深入讨论。
本次会议邀请了清华大学生物医学工程系、类脑研究中心教授宋森 ;上海市第一妇婴保健院教授、春田医管创始人段涛;深睿医疗联合创始人李一鸣;深度智耀创始人李星;连心医疗联合创始人李晓东;丹华资本合伙人张大地;宣武医院信息中心总工程师费晓璐及中电健康基金合伙人余慧为本次沙龙的嘉宾。同时,还有众多业内专家、投资人和创业者参加了本次活动。
“医疗+AI”应该何去何从,让我们一起从会议的内容中寻找答案。
利用图像发现病灶
影像检查是患者去医院检查的最常规手段,现阶段医学影像设备非常普及。现在,80%的临床治疗都需要事先进行CT、MRI等检查。通过这些设备产出的数据具有标准化特点,非常容易处理。
但在日常工作中,放射科医生一般需要耗费大量时间用于浏览医学图像。每份图像的浏览过程一般仅在五分钟左右,且长时间重复的浏览与识别会降低医生的正确率,因此误诊情况时有发生。
深睿医疗联合创始人李一鸣在会议上指出:“在如今的医疗体系中,我们没有足够的资源去支撑大量的优质医疗资源需求,这就是‘医疗+AI’的机会,通过AI来弥补当前的巨大缺口。深睿医疗便以医学影像为切入点,慢慢发掘‘医疗+AI’的价值。”
很多医生不愿意把自己的精力投入到健康人群的检查中,他们尚不能为患病的人群提供及时服务,就更没有时间去服务健康人群了。
以肺部CT为例,若是门诊时要求的CT,医生往往会做得非常细致。但如果是体检过程中做的CT,医生可能不会花时间细致浏览,如此下来,小的病灶易于被忽略。
肺结节检出(图片来源于深睿医疗)
AI技术在图像领域可以发挥很大效果,一方面,图像数据结构标准,数据量大,易于AI学习;另一方面,AI不会因为重复的劳动而感到困倦,即便AI对图像的诊断存在误判,但实际的误判率也远远低于放射科医生。
AI能把医生从重复的低水平劳动解放力中解放出来,让医生去做更多有意义的事。在未来,患者更需要人文关怀,这是冰冷的机器无法完成的。
AI能否解决医疗信息痛点
医疗信息存在三个问题:不完整、不准确、非结构化。
春雨医管创始人段涛在本次会议上谈论到了医疗信息的问题。
他认为,医疗信息出现以上问题的根源,来源于医疗资源不足,过少的优质医疗资源承担了过多的负担。卫健委虽然向医生发放了足够多的表格收集信息,但医生始终处于高负荷工作的状态,连工作都应付不来,如何花时间整理医疗数据?这导致医生对相应表格敷衍了事,表格失去了它本身的意思,收集到的数据也是残缺的、没有用处的数据。
AI可以从间接途径和直接途径两个方面来解决这个问题。
一方面,AI可以直接对病情作出分析,判断患者的身体状况。这种情况下,AI需要两种数据——病人的基因型数据和表型数据。医院可以将患者的病例提前交给AI,AI在接受基因型数据后,再接受患者自行输入或医生亲自就诊得到的表型数据,即可判断出病情。
这此情况下,医生可省去大量时间,而经过确认的数据也具有标准化、结构化、完整准确等特点。AI可通过这种方式,释放医生的时间,解决医疗数据痛点。
AI辅助分析必然存在误判率,但我们必须对机器抱有足够的耐心,因为即使是资深的医生,也会因为各种原因出现误判。据段涛医生所说,就2017年一项实验显示,在分析病情方面,某AI系统打败了95%的医生。
另一方面,AI可以就图像等数据进行标注、分析;对医疗器械产生的信息进行自动化处理;根据算法自行整理分析大数据,这些功能都会降低医生的负担,而医生有更多的精力去分析一些AI不能处理的数据,间接解决以上医疗信息痛点。
AI领域在未来如何发展?
清华大学生物医学工程系宋森教授在会议上讲述了自己从清华毕业至MIT学习这段时间与医学图像结下的不解渊源。并从中引出了两个主要问题,均关乎于AI未来的发展。
1、如何用AI技术进行小样品学习?
宋森教授认为,至今为止,有很多疾病属于小众病,但这些疾病致死率高,现在医学技术难以攻克,收集到的数据也不如常见病充足。
尽管有如此多的问题,宋森教授认为这些问题并非毫无解决可能。事实上,我们可以通过交互性标记的方法,让AI用大数据进行学习,用小数据进行训练,并从中逐渐找到规律。
2、AI是如何进行决策的?
人类在学习分析的过程中,总是会量化各种指标,即便是凭借经验作出的决策,也一定是源于遥远过去的某一件事的启示,而非凭空产生的。
AI能够通过大数据进行学习、分析作出决策,但在整个过程中,研究人员始终无法得知AI是如何作出决策。AI的分析过程就像研究人员把数据放入一个黑箱的一侧,然后从另一侧取得结果,至于中间发生了什么事,无人知晓。
但如果人们能理解AI是如何作出决策的,就能通过分析这些思考方法获得新的结论,也能改进现有AI运算中的不足之处。
宋森教授认为,如果我们能从AI角度来看问题,理解AI如何思考,就能在医疗技术上取得突飞猛进的进展。让AI对医疗的分析过程既有直觉又有推理。
基于深度学习和基于概率的贝叶斯模型为AI决策提供依据(来源于同渡资本)
投资方:盈利才是投资方参与的动机
AI的商业方式如何落地是投资方最为关心的问题。
AI的人才非常昂贵,且AI公司要不断地开发产品,拓展预约渠道,并不断补充人才。然而,收入端并没有比较明确的收入方式。很多AI企业在开始的几年只能靠不断地融资生存,它的亏损会越来越大。
即便如此,中电健康基金合伙人余慧认为:“一个是医疗行业发展不会那么快,短期确实很难看到有一个很好的商业盈利模式。但从长期来看,2018年三季度或者四季度,这个行业会出现有利好的消息。2018年的趋势,将会向上行驶,可能到2019,甚至2020年依然会保持持续向上的趋势。”
丹华资本合伙人张大地认为:“AI项目的商业模式探索不仅是中国的问题,而且是全世界的问题。我国有这么好的病源数据,国家肯定不希望在人工智能方面有所落后。所以国家在规划的过程中,已经把AI写入国家发展战略之中,很少有国家这样做。所以,我们国家不仅仅会跟随美国FDA的步伐,还会加速发展AI。这对我们目前在做AI的创业公司而言,是一个非常大的利好消息。只要坚定的做下去,价值就一定会体现出来。”
张大地在与动脉网记者的交谈中谈到:“我们不看技术属于哪个领域,AI也好,区块链也好,我们只会投未来可能盈利的项目。”所以,即使AI看上去前程似锦,但若仍不能找到好的方向解决盈利问题,投资人也会逐渐失去信心。
医院:怎样的项目值得我们付费?
宣武医院信息中心总工程师费晓璐在会议的圆桌讨论阶段点明了一些当下AI面临的实际问题。她认为AI现在仍不能落地的最大原因依然存在于技术方面。
以医院图像为例,某一AI只能对某一病种进行筛选标记,但在实际中,医生拿到一份CT,会对其进行全面的分析,而不会以一种先入为主的思维——先得知患者患有某一疾病,再用相应AI进行检测。医院没有足够的资金去部署足够的AI,这是不合理的,也是现在无法解决的问题。
所以,细分领域医院对AI的需求很高,但对于综合性大医院,现阶段AI并不能满足医院的需求。
“AI只要能够达到我们医院神经科的水平,不用企业主动提出,我们也会去主动推广,这都是有可能的。但是我是觉得,这还需要科技企业继续努力,找准问题的核心。”
新事物的发展总是蜿蜒曲折的,但毋庸置疑,AI作为人类智慧的延伸,取得人们的认可,仅仅是时间问题。我们需要对AI行业抱有信心,对AI开发者抱有有心,终有一天能看到我们梦想的科技世界。
文|赵泓维
微信|qq850860074
添加时请注明:姓名-公司-职位
后台发送关键词即可获得相关好文
网站、公众号等转载请联系授权
长按识别图中二维码,了解详情
动脉网、蛋壳研究院将面向医疗服务机构和创新企业征集基层医疗实践案例,重点涵盖医联体、远程医疗、连锁诊所、医药零售、第三方医疗服务、健康管理等领域。优秀案例将在动脉网官网、官微、活动官网及媒体矩阵进行推广,推送给10W+动脉网产业人群、1000+投资人、2000+产业人群。部分优秀案例代表将受邀参与“2018中国基层医疗创新实践论坛”做主题演讲。具体详情请长按识别图中二维码。
近期推荐
★ 用基因+区块链解决数据归属和隐私安全,有哪些企业在尝试?到底行不行?
声明:动脉网所刊载内容之知识产权为动脉网及相关权利人专属所有或持有。文中出现的采访数据均由受访者提供并确认。未经许可,禁止进行转载、摘编、复制及建立镜像等任何使用。